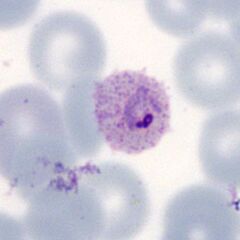

P.ovale early trophozoites gallery: Difference between revisions
From haematologyetc.co.uk
No edit summary |
No edit summary |
||
| Line 12: | Line 12: | ||
<span style="font-size:95%">'''Summary'''</span> | <span style="font-size:95%">'''Summary'''</span> | ||
<span style="font-size:95%">At the very earliest point of growth, the parasites retain a robust and large ring form. The typical species feature begin to appear as red cells may enlarge, possibly become ovoid and often develop fimbriation; typical James's dots in the red cell cytoplasm. | <span style="font-size:95%">At the very earliest point of growth, the parasites retain a robust and large ring form. The typical species feature begin to appear as red cells may enlarge, possibly become ovoid and often develop fimbriation; typical James's dots appear in the red cell cytoplasm. | ||
---- | ---- | ||
Latest revision as of 11:26, 7 May 2024
Navigation
Go Back
|